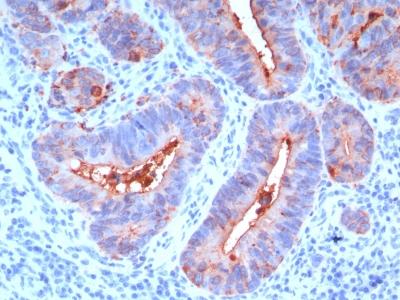

Monoclonal Antibody to Carcinoembryonic Antigen (CEA) / CD66(Clone : C66/195)
Formalin-fixed, paraffin-embedded human Colon Carcinoma stained with CEA Monoclonal Antibody (C66/195).
Roll over image to zoom in
Shipping Info:
For estimated delivery dates, please contact us at [email protected]
Format : | Purified |
Amount : | 100 µg |
Isotype : | Mouse IgG1, kappa |
Purification : | Affinity Chromatography |
Content : | 100 µg in 500 µl PBS containing 0.05% BSA and 0.05% sodium azide. Sodium azide is highly toxic. |
Storage condition : | Store the antibody at 4°C; stable for 6 months. For long-term storage; store at -20°C. Avoid repeated freeze and thaw cycles. |
This antibody recognizes proteins of 80-200kDa, identified as different members of CEA family. CEA is synthesized during development in the fetal gut and is re-expressed in increased amounts in intestinal carcinomas and several other tumors. This MAb reacts with nonspecific cross-reacting antigen (NCA) and shows a cross-reaction with human polymorphonuclear leucocytes. It shows no reaction with a variety of normal tissues and is suitable for staining of formalin/paraffin tissues. CEA is not found in benign glands, stroma, or malignant prostatic cells. Antibody to CEA is useful in detecting early foci of gastric carcinoma and in distinguishing pulmonary adenocarcinomas (60-70% are CEA+) from pleural mesotheliomas (rarely or weakly CEA+). Anti-CEA positivity is seen in adenocarcinomas from the lung, colon, stomach, esophagus, pancreas, gallbadder, urachus, salivary gland, ovary, and endocervix.
Flow Cytometry (0.5-1ug/million cells); Immunofluorescence (1-2ug/ml); Immunohistochemistry (Formalin-fixed) (1-2ug/ml for 30 minutes at RT)(Staining of formalin-fixed tissues requires heating tissue sections in 10mM Tris with 1mM EDTA, pH 9.0, for 45 min at 95 °C followed by cooling at RT for 20 minutes)
For Research Use Only. Not for use in diagnostic/therapeutics procedures.
Subcellular location: | Cell membrane, Apical cell membrane, Cell surface |
Post transnational modification: | Complex immunoreactive glycoprotein with a MW of 180 kDa comprising 60% carbohydrate. |
Tissue Specificity: | Expressed in columnar epithelial and goblet cells of the colon (at protein level) (PubMed:10436421). Found in adenocarcinomas of endodermally derived digestive system epithelium and fetal colon. |
BioGrid: | 107478. 6 interactions. |
There are currently no product reviews
|